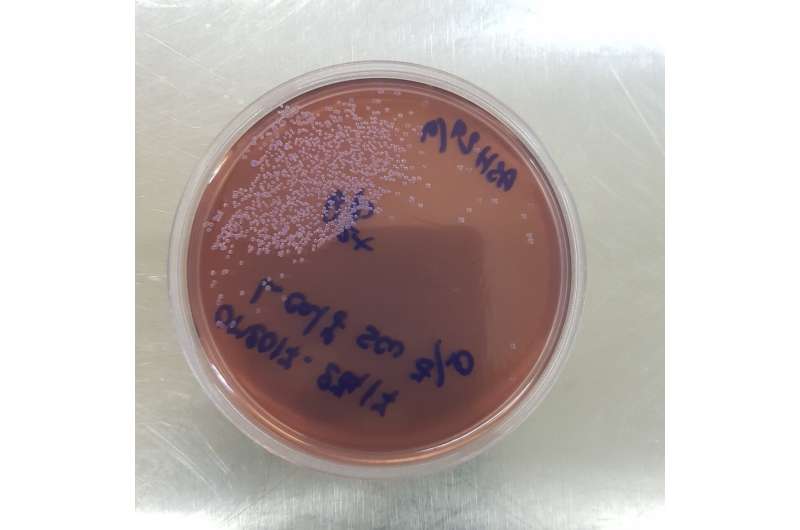
Petri dish with a brown agar base, featuring clusters of small, round, pink bacterial colonies of H. Influenza. Blue handwritten text on the lid. Credit: Paul Turner Opening the door to a vaccine for multiple childhood infections

A vaccine that tackles the bacteria that cause up to 200 million childhood infections every year could be possible, experts say.
In the first study of its kind, an international team, including those at the Wellcome Sanger Institute, the University of Oslo, the University of Oxford and the Shoklo Malaria Research Unit at Mahidol University in Thailand, analyzed new and existing Haemophilus influenzae (H. influenzae) genomes, from global samples collected between 1962 and 2023.
H. influenzae is a type of bacteria that can cause a range of infections that are widely treated with antibiotics, but despite its name, it does not cause the flu.
Published in Nature Microbiology, they uncovered extensive antibiotic resistance, with some strains resistant to most classes of antibiotics and suggest that there is an urgent need to further increase H. influenzae in global monitoring systems.
The team found that H. influenzae from around the world show surprisingly little genetic variation, suggesting that a universal vaccine that targets shared features could be developed. Potential vaccine candidates have been previously identified, and this study helps pave the way for more to be discovered.
While there is a highly effective vaccine for H. influenzae type b (Hib), which can cause childhood meningitis and other life-threatening infections, this does not work against any other strains of the same species.
One of these strains is non-typeable H. influenzae (NTHi), which is the leading cause of acute ear infections in children, causing an estimated 175 million cases per year globally. It can also cause sinusitis and conjunctivitis, and is a frequent cause of pneumonia.
Pneumonia is a potentially life-threatening disease that can also cause permanent damage to the lungs and is particularly common among young children in under-resourced countries.
In the first large-scale genome sequencing study of H. influenzae, Sanger Institute scientists and their collaborators were also the first to use genomics to comprehensively investigate H. influenzae in high-burden populations, such as those living on the Thailand-Myanmar border.
The team sequenced nasal swabs from children at the Maela camp for displaced persons in Thailand, giving 4,474 genomes, and combined these with 5,976 available published genomes of H. influenzae to give a global picture of the evolution and epidemiology of this species.
In the Maela camp, over 95% of pneumonia-associated H. influenzae were NTHi strains. This highlights how effective this bacterium is at causing disease and outcompeting both Hib and other strains of the species, even in a population unvaccinated against Hib. The team did not find any genetic variants of NTHi to be more common among pneumonia cases, suggesting they all have the same capacity to cause invasive disease.
Extensive multi-drug resistance (MDR) was common among the NTHi samples from Maela and also found worldwide.
By extensive analyses of the entire global collection of genomes, the team found that H. influenzae does not have country-specific or individually evolving lineages, which are typically seen in other major respiratory disease-causing bacteria.
Instead, despite having extremely high levels of genetic recombination, where genetic material is swapped between different bacteria during reproduction, there is low overall variation in the genome.
This is an example of pervasive negative selection, where new genetic changes are constantly removed and is promising for the prospects of future vaccine development.
Dr. Neil MacAlasdair, co-first author previously at the Wellcome Sanger Institute and the University of Oslo, and now at EMBL’s European Bioinformatics Institute (EMBL-EBI), said, “High-scale genome sequencing can reveal population-level patterns that were previously impossible to see, making it an invaluable technique in understanding the spread, impact, and evolution of infectious disease.
“By studying nearly ten thousand samples of Haemophilus influenzae, we have started to build a foundation of knowledge about the genetic diversity of the entire species relative to the strain we have a vaccine for.
“Although H. influenzae is highly recombining, there are evolutionary processes in place that preserve the majority of the genome. Understanding more about these conserved sections may hold the key to unlocking an effective vaccine which prevents disease caused by all strains of H. influenzae, reducing our reliance on broad-spectrum antibiotics.”
Dr. Anna Pöntinen, co-first author at the University of Oslo, said, “Our study shows that, unlike other bacteria that are major causes of respiratory infections, there are no isolated populations of Haemophilus influenzae in different regions. This is good news, since if there had been many different local variants, it would have been much more challenging to develop a vaccine.
“Our findings endorse our original hypothesis: that it is possible to develop a universal vaccine to protect against all types of infections caused by Haemophilus.”
Professor Paul Turner, co-senior author at the Center for Tropical Medicine and Global Health at the University of Oxford, said, “Ear infections are one of the most common reasons that antibiotics are prescribed in children, and Haemophilus influenzae is one of the most important bacteria that causes these.
“The extensive antibiotic resistance within these bacterial strains is seen both in our genomic analysis and in practice in health care settings, with only one type of effective antibiotic left in some regions of the world. We have to find new ways to tackle these infections, such as through vaccination, to ensure that everyone is protected from the twin risks of infection and antibiotic resistance.”
Professor Jukka Corander, co-senior author at the Wellcome Sanger Institute and the University of Oslo, said, “Our study brings a significant advance in understanding the epidemiology and evolution of the Haemophilus influenzae bacterial species. Disease-causing bacteria and treatment-resistant infections are not restricted by borders; we have found that they are present globally. Therefore, they represent a global threat and need to be monitored on this scale.”
More information:
Genetic population structure of Haemophilus influenzae at local and global scales, Nature Microbiology (2025). DOI: 10.1038/s41564-025-02171-9.
Wellcome Trust Sanger Institute
Citation:
Opening the door to a vaccine for multiple childhood infections (2025, October 31)
retrieved 1 November 2025
from https://medicalxpress.com/news/2025-10-door-vaccine-multiple-childhood-infections.html
This document is subject to copyright. Apart from any fair dealing for the purpose of private study or research, no
part may be reproduced without the written permission. The content is provided for information purposes only.



